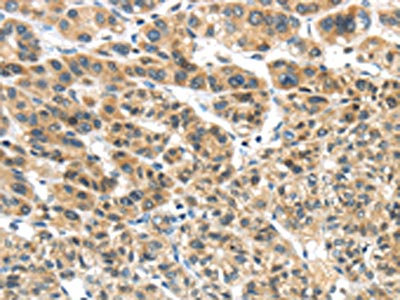

TKTL1 Antibody
-
中文名稱:TKTL1兔多克隆抗體
-
貨號(hào):CSB-PA999800
-
規(guī)格:¥1100
-
圖片:
-
The image on the left is immunohistochemistry of paraffin-embedded Human liver cancer tissue using CSB-PA999800(TKTL1 Antibody) at dilution 1/40, on the right is treated with fusion protein. (Original magnification: ×200)
-
The image on the left is immunohistochemistry of paraffin-embedded Human esophagus cancer tissue using CSB-PA999800(TKTL1 Antibody) at dilution 1/40, on the right is treated with fusion protein. (Original magnification: ×200)
-
-
其他:
產(chǎn)品詳情
-
Uniprot No.:
-
基因名:TKTL1
-
別名:TK 2 antibody; TK2 antibody; TKR antibody; TKT 2 antibody; TKT2 antibody; TKTL1 antibody; TKTL1_HUMAN antibody; Transketolase 2 antibody; Transketolase like 1 antibody; Transketolase like protein 1 antibody; Transketolase related protein antibody; transketolase-like 1 antibody; Transketolase-like protein 1 antibody; Transketolase-related protein antibody; Transketolase2 antibody
-
宿主:Rabbit
-
反應(yīng)種屬:Human
-
免疫原:Fusion protein of Human TKTL1
-
免疫原種屬:Homo sapiens (Human)
-
標(biāo)記方式:Non-conjugated
-
抗體亞型:IgG
-
純化方式:Antigen affinity purification
-
濃度:It differs from different batches. Please contact us to confirm it.
-
保存緩沖液:-20°C, pH7.4 PBS, 0.05% NaN3, 40% Glycerol
-
產(chǎn)品提供形式:Liquid
-
應(yīng)用范圍:ELISA,IHC
-
推薦稀釋比:
Application Recommended Dilution ELISA 1:2000-1:10000 IHC 1:30-1:150 -
Protocols:
-
儲(chǔ)存條件:Upon receipt, store at -20°C or -80°C. Avoid repeated freeze.
-
貨期:Basically, we can dispatch the products out in 1-3 working days after receiving your orders. Delivery time maybe differs from different purchasing way or location, please kindly consult your local distributors for specific delivery time.
-
用途:For Research Use Only. Not for use in diagnostic or therapeutic procedures.
相關(guān)產(chǎn)品
靶點(diǎn)詳情
-
功能:Catalyzes the transfer of a two-carbon ketol group from a ketose donor to an aldose acceptor, via a covalent intermediate with the cofactor thiamine pyrophosphate.
-
基因功能參考文獻(xiàn):
- The results obtained in this study suggest that pentose phosphate pathway and its key enzyme TKTL1 is altered throughout the prostate cancer tumorigenesis PMID: 30119993
- Inhibition of TKTL1 expression reverses paclitaxel resistance in human ovarian cancer cells and reduces cell proliferation. PMID: 29885837
- The research provides evidence that TKTL1 renders tumor cells more resistant to radiation therapy and to hypoxic conditions. PMID: 30044385
- Knockdown of TKTL1 additively complements cisplatin-induced cytotoxicity in the nasopharyngeal carcinoma cells by inhibiting the levels of NADPH and ribose-5-phosphate, indicating that TKTL1 may be a promising target to improve the therapeutic effect combining with cisplatin for the patients with nasopharyngeal carcinoma. PMID: 27916418
- We show that high TKTL1 in tumor tissue can lead to poor survival in colorectal cancer. TKTL1 thus can serve as a candidate marker for identifying patients at risk of recurrent disease PMID: 26650256
- Data provide evidence for an important role of TKTL1 in aerobic glycolysis and tumor promotion in melanoma that may result from defective promoter methylation. PMID: 26907172
- the cytoplasmatic expression of TKTL1 is specific for MIBC tissue compared with histopathologically benign urothelium. PMID: 25572961
- Both TKTL1 and p63 are independent prognostic factors of the poor outcome of gastric cancer patients PMID: 26406948
- TKTL1 is associated with a more aggressive behavior in human esophageal squamous cell carcinoma cells PMID: 26349965
- Data revealed exceptional occurrence of TKTL1 in a panel of malignant human cell lines in vitro suggesting that its presence was unrelated to either the rate of glucose consumption/lactic acid production or resistance against chemo- and radiotherapy. PMID: 26187043
- our results suggest that TKTL1 as a key prognostic factor may be a novel target for therapy of the patients with esophageal squamous cell carcinoma. PMID: 26032094
- In 50% of colorectal cancer patients, TKTL1 protein expression was upregulated in tumor compared to non-tumor tissue. TKTL1 expression correlated with HIF-1alpha protein expression and was induced upon hypoxic conditions. PMID: 24193262
- TKTL1 expression levels appear to decline in the course of CML with lowest levels during blast crisis. A potential reason is a shift of TKTL1-high-expressing mature granulocytes towards TKTL1-low-expressing immature cells and blasts. PMID: 24390277
- DNASEX and TKTL1 detection in patient blood is associated with poor disease-free survival rate in oral squamous cell carcinoma. PMID: 24304513
- EDIM-TKTL1 blood test revealed good concordance with FDG-PET/CT results in patients with malignancies demonstrating its efficacy to detect upregulation of glucose metabolism in primary tumors or metastases. PMID: 23130932
- Data indicate that transketolase (hTKT). shares 61% sequence identity with transketolase-like protein (TKTL1). PMID: 23261987
- No transketolase activity of TKTDelta38 can be detected for conversion of physiological sugar substrates thus arguing against an intrinsically encoded enzymatic function of TKTL1 in tumor cell metabolism PMID: 23118983
- TKLT1 is devoid of two critical histidine residues that are conserved in other TK. PMID: 22803947
- TKTL1 is dysregulated in malignant tumors of the ocular adnexa, and enhanced expression seems to predict clinical outcome, especially the tumor recurrence rate. PMID: 22658715
- TKTL1 could be a target protein for improved therapeutic strategies in some cases of lung cancer. PMID: 22445516
- TKTL1 overexpression is a new and independent predictor of survival for patients with non-small cell lung cancer PMID: 22027741
- Investigated the expression of VEGFR-1, VEGFR-2 and TKTL1 in patients with LARC treated with neoadjuvant chemoradiotherapy and cetuximab. High TKTL1 expression significantly correlated with disease free survival. PMID: 21854597
- correlation of TKTL expression with tumor stage, probability of tumor recurrence and survival in colorectal cancer PMID: 21980427
- Single Nucleotide Polymorphism in TKTL1 is associated with diabetic nephropathy. PMID: 20826743
- LDH5 is overexpressed in non-small cell lung cancer and could serve as a marker for malignancy. LDH5 correlates positively with the prognostic marker transketolase like 1 protein. PMID: 20385008
- Transketolase-like protein 1 confers resistance to serum withdrawal in vitro. PMID: 20884117
- Overexpression of TKTL1 is associated with gastric cancer. PMID: 20200485
- TKTL1 does not regulate glucose metabolism in malignant cells. PMID: 20596653
- transketolase-like 1 protein (TKTL1) is expressed in human endometrial cancer PMID: 20592357
- TKTL1 is a novel candidate oncogene that is epigenetically activated by aberrant hypomethlation and contributes to a malignant phenotype through altered glycolytic metabolism and HIF1alpha accumulation. PMID: 20103683
- Expression of pAkt, GLUT1 and TKTL1 were higher in breast cancer and DCIS than in normal tissue. PMID: 19655166
- demonstrate the presence of a second transketolase enzyme (TKTL1) in humans. This protein and its mutations and clinical implications are characterized. PMID: 15991799
- Findings strongly indicate that overexpression of TKTL1 is responsible for observed tumor-specific effects of transketolase enzyme reactions PMID: 16465194
- TKTL1 upregulation is a common phenomenon in gastric cancer and cancer of the gastroesophageal junction leading to an enhanced, oxygen-independent glucose usage which might contribute to a more aggressive tumor growth PMID: 16969476
- These results indicate that TKTL1 gene influences total transketolase activity and cell proliferation in human hepatoma cells. PMID: 17321041
- Transketolase, but not G6PD activity, was more elevated in metastasizing tumors and TKTL1 protein was significantly overexpressed in progressing tumors (p = 0.03). PMID: 18302154
- expression of transketolase-like enzyme 1 was found in 81% of granulosa cell tumors of the ovary PMID: 18394773
- Compared with grades II and III astrocytic gliomas, glioblastoma multiformes showed higher expression of TKTL1, more positive tumors, and a higher percentage of positive tumor cells. PMID: 18550470
- findings suggest that tktl1 overexpression in thyroid carcinoma is a factor which facilitates tumor growth and progression PMID: 18615628
- results suggest that both Transketolase-like enzyme 1 (TKTL1) and p-Akt protein play an important role in the progression of cervical neoplasia PMID: 18686341
- TKTL1 overexpression may be considered not only as a new tumor marker but also as a good target for anticancer therapy. PMID: 19065656
- TKTL1 plays an important role in total transketolase activity and cells proliferation in uterine cervix cancer PMID: 19331662
- RNAi-mediated suppression of TKTL1 in hepatoma cells significantly reduces total transketolase activity and inhibits proliferation. Findings suggest that TKTL1 plays an important role in glycometabolism and cell cycle progression in tumors. PMID: 17321041
顯示更多
收起更多
-
亞細(xì)胞定位:Cytoplasm. Nucleus. Note=Predominantly cytoplasmic and to a lesser extent also nuclear (PubMed:16969476).
-
蛋白家族:Transketolase family
-
組織特異性:Expressed in fetal and adult heart, brain, lung, liver, and kidney, and in adult placenta, skeletal muscle and pancreas. Up-regulated in various epithelial tumors.
-
數(shù)據(jù)庫(kù)鏈接:
Most popular with customers
-
-
YWHAB Recombinant Monoclonal Antibody
Applications: ELISA, WB, IHC, IF, FC
Species Reactivity: Human, Mouse, Rat
-
Phospho-YAP1 (S127) Recombinant Monoclonal Antibody
Applications: ELISA, WB, IHC
Species Reactivity: Human
-
-
-
-
-